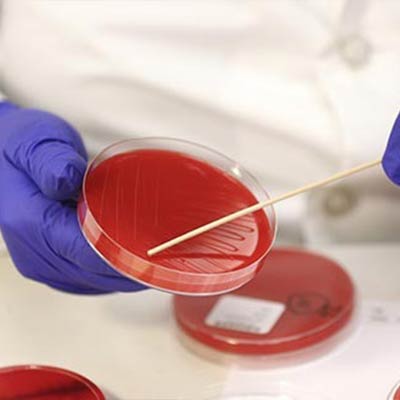
Bacteriology

Unlocking Animal Health Through Science
Precision. Innovation. Care.
At Averroes Laboratories, we are redefining veterinary diagnostics with advanced microscopic analysis and state-of-the-art lab testing for livestock and pets.

About us
Welcome to Averroes
Averroes Laboratories is a leading ISO-certified veterinary testing lab committed to improving animal health through reliable and accurate diagnostics. Our team of skilled professionals uses advanced microscopy and innovative testing techniques to detect diseases early, support preventative care, and help farmers, pet owners, and vets make informed decisions.
Featured Tests
Testimonials
Averroes Laboratories: Empowering veterinary excellence with precise diagnostics for healthier animals.
Averroes helped me identify a health issue in my herd before it spread. Their team is responsive, and the results were spot-on. Highly recommended!

Imran A.
Reliable and professional lab with quick turnaround times. As a vet, I trust them for all my diagnostic needs.

Dr. Sana Khalid
Partnering with Averroes Laboratories has transformed our poultry health management. Their precise diagnostic services and expert guidance have significantly reduced disease outbreaks, helping us maintain optimal flock health. Truly a trusted partner!

Mr. Khalid
ARL’s diagnostic accuracy and prompt reporting have been instrumental in keeping our livestock healthy. Their dedication to animal well-being sets them apart from other labs. Excellent support and expertise!